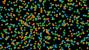

Media Manager
Media Files
Files in [root]

- 0c34d.jpg
- 1000×583
- 2017/07/27 14:37
- 74.1 KB

- 0fd1e.jpg
- 400×282
- 2017/07/26 17:01
- 34.9 KB

- 0030c.jpg
- 250×250
- 2017/07/26 16:23
- 27.2 KB

- 01733.jpg
- 250×250
- 2017/07/25 19:03
- 2.6 KB

- 0222f.jpg
- 500×200
- 2017/07/25 14:24
- 29.1 KB

- 04623.jpg
- 320×585
- 2017/07/25 19:00
- 93.1 KB

- 056e2.jpg
- 300×300
- 2017/07/26 16:38
- 12.6 KB

- 06624.jpg
- 308×450
- 2017/07/27 14:54
- 42.3 KB

- 07449.jpg
- 226×350
- 2017/07/26 16:59
- 8.5 KB

- 08174.jpg
- 200×198
- 2017/07/25 15:06
- 7.5 KB

- 09b18.jpg
- 450×282
- 2017/07/25 18:52
- 58.7 KB

- 09889.jpg.png
- 500×354
- 2017/07/25 14:24
- 373.2 KB

- 1a3e5.jpg
- 221×134
- 2017/07/25 18:57
- 17.6 KB

- 2bc80.gif
- 194×266
- 2017/07/26 15:24
- 3.4 KB

- 2bda6.jpg
- 250×250
- 2017/07/26 16:23
- 39.2 KB

- 2c72f.gif
- 300×150
- 2017/07/25 19:03
- 4.5 KB

- 2d4d5.jpg
- 250×334
- 2017/07/25 18:54
- 37.8 KB

- 2e610.jpg
- 320×317
- 2017/07/24 15:25
- 30.1 KB

- 2f1f4.jpg
- 300×214
- 2017/07/25 18:23
- 7.9 KB

- 2f5c3.jpg
- 200×200
- 2017/07/25 14:08
- 6 KB

- 2f189.jpg
- 300×300
- 2017/07/27 15:14
- 36.3 KB

- 2fb20.jpg
- 500×314
- 2017/07/27 15:16
- 47.9 KB

- 3aa7a.jpg
- 400×100
- 2017/07/25 19:22
- 4.1 KB

- 3ae4c.jpg
- 350×140
- 2017/07/24 15:37
- 14.2 KB

- 3bfe5.jpg
- 399×268
- 2017/07/25 14:47
- 14.3 KB

- 3ca9a.jpg
- 450×245
- 2017/07/27 14:55
- 27 KB

- 3e48d.jpg
- 450×338
- 2017/07/25 18:31
- 12.6 KB

- 3fa6c.jpg
- 400×300
- 2017/07/25 14:47
- 13.1 KB

- 4eeef.jpg
- 300×252
- 2017/07/25 18:52
- 38.1 KB

- 4fadb.jpg.gif
- 300×323
- 2017/07/26 16:13
- 17.5 KB

- 5d9d0.gif
- 311×288
- 2017/07/24 15:01
- 8.8 KB

- 6b26e.jpg
- 350×270
- 2017/07/27 15:12
- 22 KB

- 6c808.jpg
- 300×201
- 2017/07/27 14:42
- 28.1 KB

- 6eab5.jpg
- 250×250
- 2017/07/25 18:34
- 6 KB

- 6fe07.jpg
- 442×296
- 2017/07/27 14:42
- 47.9 KB

- 7b1a6.jpg
- 400×300
- 2017/07/25 14:47
- 16 KB

- 7e4b4.jpg
- 300×300
- 2017/07/26 16:40
- 12.3 KB

- 7eec7.jpg
- 572×168
- 2017/07/24 15:39
- 15 KB

- 7ff59.jpg
- 300×300
- 2017/07/27 14:57
- 5.2 KB

- 8a8d2.jpg
- 450×327
- 2017/07/26 17:02
- 41.7 KB

- 8a250.jpg
- 250×250
- 2017/07/26 16:22
- 21.6 KB

- 8d922.jpg
- 350×226
- 2017/07/25 17:52
- 15.6 KB

- 8ebdd.jpg
- 400×257
- 2017/07/25 14:47
- 9.9 KB

- 8f082.jpg
- 357×307
- 2017/07/25 18:59
- 21.4 KB

- 8f15a.gif
- 220×260
- 2017/07/24 15:21
- 3.7 KB

- 9a413.jpg
- 320×239
- 2017/07/24 15:25
- 31.5 KB

- 9aeba.jpg
- 300×231
- 2017/07/26 16:18
- 6.2 KB

- 9f6b9.jpg
- 323×235
- 2017/07/25 19:22
- 10.5 KB

- 9f207.jpg
- 450×413
- 2017/07/27 15:13
- 39 KB

- 10a8d.jpg
- 300×150
- 2017/07/27 14:47
- 3 KB

- 15c4a.jpg
- 350×378
- 2017/07/26 16:13
- 31.6 KB

- 16e28.jpg
- 350×235
- 2017/07/26 16:59
- 28.2 KB

- 25c57.jpg
- 400×277
- 2017/07/26 15:28
- 75.6 KB

- 29a35.jpg
- 450×150
- 2017/07/26 16:58
- 10.5 KB

- 35c90.jpg
- 311×277
- 2017/07/27 15:18
- 24 KB

- 39da5.jpg
- 350×223
- 2017/07/26 16:49
- 23.2 KB

- 41a0b.jpg
- 329×150
- 2017/07/25 19:15
- 7.7 KB

- 48d81.jpg
- 500×399
- 2017/07/27 15:17
- 106.4 KB
- 57b58.jpg
- 350×197
- 2017/07/25 14:13
- 38.2 KB

- 57b92.jpg
- 350×313
- 2017/07/26 16:20
- 56.3 KB

- 62cb5.jpg
- 250×200
- 2017/07/27 14:54
- 6.7 KB

- 65beb.jpg
- 300×299
- 2017/07/26 16:13
- 22 KB

- 67ecc.jpg
- 320×137
- 2017/07/26 16:27
- 2.8 KB

- 77a05.jpg
- 98×96
- 2017/07/25 17:58
- 2.1 KB

- 78f61.jpg
- 250×250
- 2017/07/26 16:22
- 25.7 KB

- 81f7d.jpg
- 1000×359
- 2017/07/27 14:37
- 51.7 KB

- 82b39.jpg
- 300×204
- 2017/07/26 16:48
- 15.7 KB

- 82f6c.jpg
- 251×331
- 2017/07/27 14:54
- 31 KB

- 87eb5.jpg
- 350×263
- 2017/07/27 14:49
- 31.9 KB

- 100ef.jpg
- 400×102
- 2017/07/25 14:24
- 4.7 KB

- 138c2.jpg
- 250×221
- 2017/07/24 15:06
- 25.5 KB

- 234ed.jpg
- 320×471
- 2017/07/26 15:29
- 44.6 KB

- 248af.jpg
- 350×350
- 2017/07/25 14:05
- 14.9 KB

- 251d0.jpg
- 400×133
- 2017/07/25 14:47
- 6.6 KB

- 356a2.jpg
- 250×250
- 2017/07/25 14:23
- 8.2 KB

- 359a5.jpg
- 350×484
- 2017/07/26 16:50
- 47 KB

- 410ee.gif
- 150×271
- 2017/07/25 19:13
- 3.8 KB

- 456b7.jpg
- 640×394
- 2017/07/24 15:14
- 87.5 KB

- 686fd.jpg
- 350×200
- 2017/07/26 16:50
- 29.8 KB

- 709b5.jpg
- 350×100
- 2017/07/25 18:01
- 5.6 KB

- 715c3.jpg
- 280×285
- 2017/07/26 15:54
- 16.7 KB

- 788d8.jpg
- 400×235
- 2017/07/24 15:37
- 19.9 KB

- 797b6.jpg
- 300×410
- 2017/07/25 17:52
- 39.3 KB

- 822f7.jpg
- 300×300
- 2017/07/26 16:38
- 12.5 KB

- 834dd.jpg
- 350×350
- 2017/07/26 16:15
- 6.6 KB

- 862d9.jpg
- 400×200
- 2017/07/25 14:24
- 7.2 KB

- 899c9.jpg
- 400×268
- 2017/07/25 19:43
- 40.1 KB

- 958f2.jpg
- 250×250
- 2017/07/25 19:11
- 8.5 KB

- 2932e.jpg
- 450×277
- 2017/07/27 15:18
- 34 KB

- 3314c.jpg
- 400×100
- 2017/07/24 15:31
- 4.6 KB

- 3318c.jpg
- 300×231
- 2017/07/26 16:18
- 18.9 KB

- 3544a.jpg
- 350×220
- 2017/07/25 18:27
- 19.3 KB

- 5508e.jpg
- 350×234
- 2017/07/26 15:54
- 5.9 KB

- 5930f.jpg
- 300×225
- 2017/07/24 15:25
- 29.1 KB

- 6779e.gif
- 220×260
- 2017/07/24 15:21
- 3.8 KB

- 8069b.jpg
- 442×200
- 2017/07/25 18:34
- 9.6 KB

- 8677e.jpg
- 400×300
- 2017/07/27 14:42
- 23.1 KB

- 12520.jpg
- 900×450
- 2017/07/26 16:24
- 86.9 KB

- 17372.jpg
- 300×362
- 2017/07/27 14:47
- 28 KB

- 19327.jpg
- 300×223
- 2017/07/24 15:25
- 25.2 KB

- 23054.gif
- 224×160
- 2017/07/26 16:31
- 1.9 KB

- 24858.jpg
- 450×433
- 2017/07/27 15:13
- 83.3 KB

- 32807.jpg
- 350×259
- 2017/07/25 17:52
- 43 KB

- 33431.jpg
- 640×426
- 2017/07/24 15:16
- 68.7 KB

- 34192.jpg
- 250×250
- 2017/07/25 14:23
- 8.6 KB

- 35907.jpg
- 300×357
- 2017/07/25 18:51
- 21.2 KB

- 36293.jpg
- 220×194
- 2017/07/24 15:06
- 28.5 KB

- 41362.jpg
- 214×212
- 2017/07/25 18:00
- 8.4 KB

- 49928.jpg
- 300×164
- 2017/07/25 17:52
- 8.7 KB

- 50726.jpg
- 500×399
- 2017/07/27 15:16
- 55.2 KB

- 57267.jpg
- 450×227
- 2017/07/25 19:43
- 22.6 KB

- 57963.jpg
- 400×233
- 2017/07/26 16:47
- 17.7 KB

- 68165.jpg
- 294×151
- 2017/07/27 14:45
- 2.6 KB

- 70361.jpg
- 200×150
- 2017/07/24 15:14
- 3.6 KB

- 70671.jpg
- 400×172
- 2017/07/24 15:31
- 9.5 KB

- 76563.jpg
- 480×146
- 2017/07/25 19:47
- 20.1 KB

- 80116.jpg
- 400×100
- 2017/07/25 19:33
- 4.4 KB

- 81852.jpg
- 460×345
- 2017/07/26 15:29
- 32.4 KB

- a9aef.jpg
- 350×100
- 2017/07/25 18:01
- 5.6 KB

- a12ce.jpg.png
- 500×285
- 2017/07/24 15:37
- 79.8 KB

- a29de.gif
- 450×267
- 2017/07/25 19:47
- 5.7 KB

- a53ec.jpg
- 450×300
- 2017/07/26 17:02
- 59.1 KB

- a81ad.jpg
- 200×160
- 2017/07/26 16:31
- 3.1 KB

- a1036.jpg
- 400×172
- 2017/07/24 15:31
- 8.6 KB

- a4839.gif
- 281×89
- 2017/07/27 14:45
- 4 KB

- a4913.gif
- 200×199
- 2017/07/26 16:32
- 1.5 KB

- a8591.jpg
- 436×300
- 2017/07/27 14:39
- 9.6 KB

- a_sunday_seurat.jpg
- 500×330
- 2017/10/13 14:13
- 60 KB

- a_sunday_seurat_crop.jpg
- 224×400
- 2017/10/13 14:13
- 33.9 KB

- aae01.jpg
- 400×300
- 2017/07/25 14:47
- 17.4 KB

- acceleration.gif
- 512×288
- 2017/08/22 15:10
- 2.2 MB

- acceleration_mov.mp4
- 2017/07/25 18:20
- 177.8 KB

- achromatic_bw.jpg
- 300×300
- 2017/08/25 15:50
- 43.3 KB

- achromatic_color.jpg
- 300×300
- 2017/08/25 15:50
- 54.8 KB

- ad10f.jpg.png
- 500×286
- 2017/07/24 15:06
- 184.7 KB

- add_color.gif
- 320×240
- 2017/08/22 15:11
- 523.1 KB

- additive_rgb.mp4
- 2017/07/26 16:39
- 84.1 KB

- additivecolor.png
- 2000×2000
- 2017/09/01 15:04
- 89.6 KB

- additivergbcolor.gif
- 500×281
- 2017/09/01 15:04
- 762.7 KB

- aec19.jpg
- 400×300
- 2017/07/25 14:47
- 18 KB

- afc2a.jpg
- 300×214
- 2017/07/26 15:31
- 11.1 KB

- b03d1.jpg
- 300×360
- 2017/07/25 19:15
- 24.8 KB

- b2e8b.jpg
- 400×300
- 2017/07/25 14:47
- 25 KB

- b7d48.jpg
- 400×300
- 2017/07/27 14:42
- 29.3 KB

- b9dca.jpg
- 250×391
- 2017/07/26 16:56
- 32.3 KB

- b99c2.jpg
- 400×300
- 2017/07/25 14:47
- 15.1 KB

- b657e.jpg
- 500×333
- 2017/07/27 14:42
- 35.5 KB

- b5892.jpg
- 400×300
- 2017/07/25 14:47
- 18.2 KB

- b7634.gif
- 400×388
- 2017/07/25 18:26
- 23.5 KB

- ba8f2.jpg
- 1000×618
- 2017/07/25 18:44
- 75.6 KB

- bb6ed.jpg
- 256×300
- 2017/07/24 15:20
- 10.7 KB

- bbeab.jpg
- 350×350
- 2017/07/26 16:15
- 6.3 KB

- bddf9.jpg
- 400×300
- 2017/07/25 14:47
- 3.8 KB

- c6ad0.jpg
- 400×557
- 2017/07/25 17:52
- 67.9 KB

- c7c6f.gif
- 400×438
- 2017/07/25 18:26
- 8.4 KB

- c15b9.jpg
- 500×314
- 2017/07/27 15:16
- 50.2 KB

- c91ba.gif
- 248×82
- 2017/07/27 15:05
- 1022 B

- c92cb.gif
- 350×349
- 2017/07/25 18:59
- 11.9 KB

- c7758.gif
- 500×400
- 2017/07/24 15:10
- 10.4 KB

- ca4b0.jpg
- 300×336
- 2017/07/27 14:50
- 23.7 KB

- caa64.gif
- 400×385
- 2017/07/27 15:10
- 29.2 KB

- cb1af.jpg
- 400×292
- 2017/07/25 18:32
- 53.3 KB

- cc6cf.jpg
- 350×347
- 2017/07/26 16:56
- 5.7 KB

- cf6f9.jpg
- 400×300
- 2017/07/25 14:47
- 20.2 KB

- change-time.mp4
- 2017/07/25 15:15
- 268.3 KB

- change_time.gif
- 320×240
- 2017/08/22 15:11
- 533.6 KB

- common_fate-shape.gif
- 320×240
- 2017/08/22 15:12
- 230.1 KB

- common_fate-swarm.gif
- 480×270
- 2017/08/22 15:14
- 4.6 MB

- common_fate_shape.mp4
- 2017/07/25 14:14
- 46.8 KB

- common_fate_swarm.mp4
- 2017/07/25 14:14
- 1.1 MB

- comp_color1.jpg
- 250×322
- 2017/09/15 14:03
- 11.9 KB

- comp_color2.jpg
- 250×324
- 2017/09/15 14:03
- 12.1 KB

- compression.gif
- 640×360
- 2017/08/22 15:15
- 711.1 KB

- compression.mp4
- 2017/07/25 14:38
- 151.1 KB

- continuity-direction.jpg
- 350×81
- 2017/09/22 13:51
- 2.7 KB

- d2a07.jpg
- 420×208
- 2017/07/25 18:31
- 5.4 KB

- d11bc.jpg
- 350×298
- 2017/07/26 16:56
- 37.9 KB

- d34cf.jpg
- 500×201
- 2017/07/25 19:03
- 29.5 KB

- d44b6.jpg
- 300×357
- 2017/07/25 18:51
- 18.7 KB

- d64c7.jpg
- 420×111
- 2017/07/25 19:17
- 10.2 KB

- d487c.jpg
- 350×266
- 2017/07/25 19:16
- 21.3 KB

- da1fc.jpg
- 320×239
- 2017/07/24 15:25
- 37.7 KB

- db044.jpg
- 350×467
- 2017/07/25 18:53
- 72.1 KB

- db22f.jpg
- 400×172
- 2017/07/24 15:31
- 8.8 KB

- dc43c.jpg
- 200×198
- 2017/07/25 14:08
- 6.6 KB

- dcdb5.jpg
- 320×321
- 2017/07/26 16:19
- 43 KB

- deecc.jpg
- 400×300
- 2017/07/25 14:47
- 12.2 KB

- df903.jpg
- 345×136
- 2017/07/25 18:57
- 17.9 KB

- dfabe.jpg
- 400×300
- 2017/07/25 14:47
- 23.5 KB

- direction-2.gif
- 320×240
- 2017/08/22 15:16
- 115 KB

- direction.mp4
- 2017/07/25 18:07
- 101.3 KB

- discont_direction.jpg
- 350×81
- 2017/09/22 13:51
- 3.3 KB

- dynamic.gif
- 500×300
- 2017/07/25 18:13
- 6.9 KB

- e1f06.jpg
- 138×90
- 2017/07/25 17:59
- 2.2 KB

- e7fe3.jpg
- 400×180
- 2017/07/25 19:16
- 16.1 KB

- e53a8.jpg
- 160×160
- 2017/07/25 14:24
- 3.5 KB

- e76a4.jpg
- 400×300
- 2017/07/25 14:47
- 17.8 KB

- eb182.jpg
- 400×300
- 2017/07/25 14:47
- 22 KB

- eb362.jpg
- 400×400
- 2017/07/24 15:31
- 10.9 KB

- ec230.jpg
- 360×230
- 2017/07/24 15:25
- 25.5 KB

- eca1f.jpg
- 350×263
- 2017/07/25 17:52
- 19.7 KB

- ed649.jpg
- 250×333
- 2017/07/27 15:12
- 24.8 KB

- ee304.jpg
- 200×200
- 2017/07/25 14:08
- 8.1 KB

- ee693.jpg
- 400×244
- 2017/07/24 15:25
- 7.6 KB

- elastic.gif
- 640×360
- 2017/08/22 15:16
- 781.1 KB

- elastic.mp4
- 2017/07/25 14:38
- 170.6 KB

- equilibrium.jpg
- 360×203
- 2017/07/27 15:25
- 5.6 KB

- expansion.gif
- 640×360
- 2017/08/22 15:15
- 1.4 MB

- expansion.mp4
- 2017/07/25 14:38
- 210 KB

- f59eb.jpg
- 320×184
- 2017/07/27 14:56
- 19.4 KB

- f177e.jpg
- 463×65
- 2017/07/25 14:05
- 4.8 KB

- f383f.jpg
- 166×111
- 2017/07/25 18:34
- 5.2 KB

- fc7e7.jpg
- 300×300
- 2017/07/27 14:44
- 12.7 KB

- fccd3.gif
- 412×92
- 2017/07/25 19:03
- 2.8 KB

- fe6a4.jpg
- 450×356
- 2017/07/26 16:20
- 74.8 KB

- fefaa.jpg
- 350×283
- 2017/07/25 18:27
- 22.6 KB

- fig-gr_reversal.jpg
- 300×300
- 2017/10/06 13:36
- 5.6 KB

- hue_brightness.jpg
- 400×172
- 2017/07/25 19:27
- 8.7 KB

- laocoon.jpg
- 400×400
- 2017/07/25 18:16
- 32 KB

- lossy-vs-losslee.jpg
- 1000×618
- 2017/07/25 18:46
- 75.6 KB

- menkaure.jpg
- 251×500
- 2017/07/25 18:14
- 18.1 KB

- momentum_heavy.gif
- 512×288
- 2017/08/22 15:17
- 2.2 MB

- momentum_heavy.mp4
- 2017/07/26 15:33
- 312.1 KB

- momentum_light.gif
- 512×288
- 2017/08/22 15:17
- 2.2 MB

- momentum_light.mp4
- 2017/07/26 15:33
- 207.2 KB

- motion-parallax.mp4
- 2017/07/25 19:41
- 888.2 KB

- motion_parallax.gif
- 320×240
- 2017/08/22 15:18
- 1.1 MB

- motionparallax.mp4
- 2017/07/25 19:40
- 5.8 MB

- nude_des.jpg
- 300×501
- 2017/07/25 18:14
- 54.3 KB

- orientation.gif
- 320×240
- 2017/08/22 15:21
- 27.5 KB

- orientation.mp4
- 2017/07/26 16:07
- 93.1 KB

- position.gif
- 320×240
- 2017/08/22 15:22
- 110.7 KB

- position.mp4
- 2017/07/26 16:05
- 80.9 KB

- prim_add_color.gif
- 320×240
- 2017/08/22 15:22
- 425.4 KB

- progression.gif
- 480×200
- 2017/08/22 15:23
- 205.8 KB

- progression.mp4
- 2017/07/26 16:43
- 75.2 KB

- progression_shape.gif
- 480×200
- 2017/10/20 14:15
- 4.5 KB

- progression_shape2.gif
- 480×156
- 2017/10/20 14:18
- 4.4 KB

- proportion.gif
- 320×240
- 2017/08/25 15:12
- 135.2 KB

- proportion.mp4
- 2017/07/26 16:03
- 82.3 KB

- raft_proximity.jpg
- 706×236
- 2017/07/26 16:53
- 39.6 KB

- rothko.jpg
- 300×382
- 2017/07/25 18:13
- 6.7 KB

- saturation_highorange.jpg
- 190×200
- 2017/10/27 14:51
- 24.7 KB

- saturation_loworange.jpg
- 190×200
- 2017/10/27 14:51
- 24.6 KB

- saturation_noorange.jpg
- 190×200
- 2017/10/27 14:51
- 24.5 KB

- shape.gif
- 320×240
- 2017/08/25 15:12
- 146 KB

- shape.mp4
- 2017/07/26 16:04
- 104.4 KB

- size.gif
- 320×240
- 2017/08/25 15:12
- 135.3 KB

- size.mp4
- 2017/07/26 16:02
- 82.5 KB

- speed.gif
- 320×240
- 2017/08/22 15:26
- 244.2 KB

- speed.mp4
- 2017/07/26 16:08
- 191.9 KB

- stasis.gif
- 320×240
- 2017/08/22 15:26
- 130 KB

- stasis.mp4
- 2017/07/26 16:09
- 68.7 KB

- stress-release.gif
- 640×360
- 2017/08/22 15:28
- 524.9 KB

- stress-release.mp4
- 2017/07/25 14:38
- 155.3 KB

- subtractive_cmyk.gif
- 320×240
- 2017/08/22 15:22
- 437.1 KB

- subtractive_cmyk.mp4
- 2017/07/26 16:40
- 81.8 KB

- subtractivecmycolor.gif
- 500×281
- 2017/09/01 15:34
- 375.9 KB

- subtractivecolor.png
- 1200×1200
- 2017/09/01 15:34
- 53.1 KB

- sym-asym-v1.gif
- 500×400
- 2017/09/08 15:21
- 7.9 KB

- sym-asym-v2.gif
- 500×362
- 2017/09/08 15:17
- 8.6 KB

- tension.gif
- 640×360
- 2017/08/22 15:27
- 815.1 KB

- tension.mp4
- 2017/07/25 14:38
- 97.8 KB

- texture.gif
- 320×240
- 2017/08/25 15:13
- 341.3 KB

- texture.mp4
- 2017/07/26 16:08
- 242.4 KB

- texture_squares.jpg
- 520×148
- 2017/08/25 15:39
- 21 KB

- torsion.gif
- 640×360
- 2017/08/22 15:28
- 734.1 KB

- torsion.mp4
- 2017/07/25 14:38
- 142.1 KB

